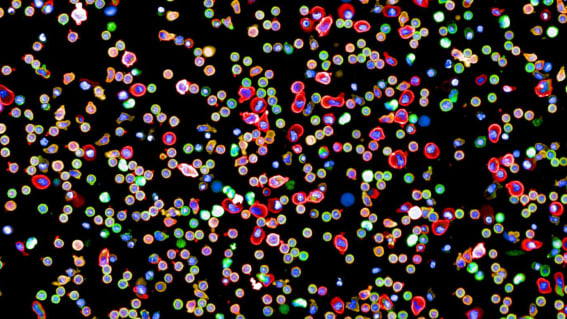
image

Das Immunsystem des Menschen besteht aus vielen hochspezialisierten Zellen, von denen einige ungebunden und einzeln durch den Körper wandern, um nach Anzeichen von Verletzungen oder Krankheitserregern zu suchen. Sobald diese Zellen eine Bedrohung erkennen, müssen sie die Nachricht an andere Zellen weitergeben, um eine wirksame Immunreaktion einzuleiten. Eine Möglichkeit der Signalübertragung von Zelle zu Zelle sind Oberflächenproteine, die sich an passende Rezeptorproteine auf der Oberfläche anderer Zellen binden.
Die Kenntnis all dieser Kommunikationswege und der entsprechenden Wechselwirkungen war aber aufgrund der ungeheuren Vielfalt von Oberflächenstrukturen auf Immunzellen bislang unvollständig.
Erste detaillierte Netzwerkkarte
Diese Lücken füllen nun Forschende des Wellcome Sanger Institute (GB) und der
ETH Zürich. In einem gemeinsamem Effort haben sie erstmals eine vollständige Netzwerkkarte dieser Rezeptorverbindungen erstellt. Damit zeigen sie detailliert auf, wie Immunzellen im gesamten Körper miteinander wechselwirken und kommunizieren. Die entsprechende Studie ist soeben in der Fachzeitschrift
«Nature» erschienen.
Will man neue Immuntherapien gegen Krankheiten entwickeln, ist ein tiefes Verständnis der Wechselwirkungen zwischen Immunzellen und der Einbindung dieser Kommunikation im menschlichen Körper entscheidend.
Mithilfe dieser Karte können Forschende erkennen, wie sich verschiedene Krankheiten auf das Immunsystem als Ganzes auswirken. Es lassen sich zudem neue Wirkstoffe erforschen, die an verschiedene Oberflächenproteine der Immunzellen binden. Zelloberflächenproteine dienen häufiger als jeder andere Proteintyp als Zielstruktur für neue Medikamente, da sie für Wirkstoffe zugänglich sind und einen starken Einfluss auf die Signale haben, die eine Zelle empfängt.
Im Rahmen dieser Studie entdeckten die Forschenden zudem viele bisher unbekannte Verbindungen, die ein neues Licht auf die Organisation der Immunabwehr des Körpers werfen. Die Forschenden erhalten damit auch Antworten auf Fragen zu therapeutischen Zielen von Immuntherapien, die bereits an Patientinnen und Patienten angewendet werden. In Zukunft könnte die offen zugängliche Karte des Immunsystems auch bei der Suche nach neuen (Immun-)Therapien von entscheidender Bedeutung sein.
Immuntherapien haben ihr grosses Potenzial zur Behandlung von Krankheiten wie bestimmten Krebsarten bereits unter Beweis gestellt. Sie wirken manchmal jedoch nur bei bestimmten Patientengruppen und gewissen Erkrankungen. Mithilfe der neuen Netzwerkkarte der Immunrezeptorverbindungen können Forschende erklären, warum Immuntherapien nur bei einer Untergruppe von Patienten wirken. Die Karte kann auch dabei helfen, neue Zielproteine aufzufinden für die Entwicklung künftiger Immuntherapien für Patienten, die derzeit nicht von solchen Behandlungen profitieren.
Ein tiefgreifendes Verständnis der Zell-Zell-Signale im Immunsystem ist auch notwendig, um Autoimmunkrankheiten zu verhindern und zu behandeln. Autoimmunerkrankungen entstehen dadurch, dass das Immunsystem interne Signale verwechselt und eigene Zellen als fremd erkennt und angreift.
Oberflächenproteine sind Schlüssel
Für die Studie hat das Forschungsteam einen fast vollständigen Satz von Oberflächenproteinen, die Immunzellen physisch miteinander verbinden, isoliert und untersucht. Anschliessend erstellten die Forschenden mit Hilfe umfangreicher rechnerischer und mathematischer Analysen eine Karte, welche die Zelltypen, Botenstoffe und die relative Geschwindigkeit der einzelnen «Gespräche» zwischen den Immunzellen zeigt.
Die Erstellung dieser Netzwerkkarte des Immunsystems erforderte viel Entwicklungsarbeit und Aufwand. Jede Immunzelle kann Hunderte von verschiedenen Oberflächenproteinen und Rezeptoren aufweisen, und die Interaktionen zwischen diesen Proteinen sind oft so flüchtig, dass die Forschenden spezielle Methoden entwickeln mussten, um die Verbindungen zu charakterisieren.
Berend Snijder, Professor am Institut für Molekulare Systembiologie der ETH Zürich und Co-Autor der Studie, sagt: «Diese Forschung hat ein unglaubliches neues Werkzeug hervorgebracht. Dank ihm können wir nun herauszufinden, welche Proteine und Signalwege als Ansatzstellen für neue Medikamente dienen könnten. Es kann auch Aufschluss darüber geben, ob sich ein Medikament auf andere Signalwege, die Nebenwirkungen verursachen können, auswirkt.» All diese Informationen könnten dazu beitragen, dass potenziell geeignete Wirkstoffkandidaten in klinischen Studien untersucht würden.